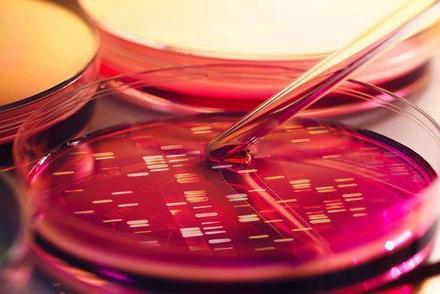
Wisconsin criminal defense attorney, Wisconsin defense lawyer, your rights

New DNA Collection Law Makes More Work for Wisconsin Law Enforcement
The advent of DNA evidence has allowed police to solve crimes more easily and with greater certainty than before. Now, new DNA evidence collection requirements are pushing the state to expand its workforce to keep up with the increasing flow of samples that will soon come through state labs. These new requirements may keep Wisconsin citizens safer, but some members of the public are also concerned about privacy rights. In some circumstances, the new collection requirements come into effect before a person is convicted, so the state may end up logging DNA from innocent people.
The advent of DNA evidence has allowed police to solve crimes more easily and with greater certainty than before. Now, new DNA evidence collection requirements are pushing the state to expand its workforce to keep up with the increasing flow of samples that will soon come through state labs. These new requirements may keep Wisconsin citizens safer, but some members of the public are also concerned about privacy rights. In some circumstances, the new collection requirements come into effect before a person is convicted, so the state may end up logging DNA from innocent people.
New Collection Requirements
The new collection requirements for Wisconsin police departments become active on April 1st of next year, and they greatly expand the amount of DNA that the state is required to collect. As it stands, Wisconsin only collects DNA from people who have been convicted, and even then, only people whose convictions were for felonies or sex-related misdemeanors. These new requirements instruct the police to take samples from a broader set of people.
Now, everyone convicted of any misdemeanor must surrender their DNA, and people who have been arrested for a violent felony must submit to DNA testing before they are even convicted. However, the state does suspend processing of their samples, while a judge determines whether there was actually probable cause to arrest the person. State departments expect this new law to increase their workload by more than 500 percent. At present, the state collects approximately 12,000 DNA samples a year. Experts project that the new law will increase that number to closer to 77,000 samples. Such a massive increase has provoked an outcry from rights advocates.
The Controversy
Advocates of citizens’ privacy rights have voiced concern about the broad expansion of DNA collection, especially with regard to people who have yet to be convicted of a crime. There is a great deal of concern that the expansion of DNA databanks will lead to a severe decrease in genetic privacy as technology advances and DNA becomes more and more important. For instance, there have already been examples of law enforcement agencies allowing scientists to use their DNA databases for research. This invades the privacy of the people in the database, and it deprives them of their right to consent to participating in the research. Even more importantly, some advocates raise concerns about the security of these databases. A person may be able to breach the database, and in doing so publish a person's private DNA profile to the world.
DNA testing is just one example of the cutting edge nature of criminal defense work. If you have recently been charged with a crime, contact an experienced Milwaukee criminal defense attorney today. Our firm is here to make sure you have the most up to date information to help defend you.







